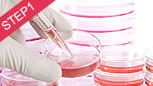

宫颈糜烂三种程度,早发现!




宫颈糜烂三种程度,早发现!

糜烂面小于整个宫颈面积的l/3,无明显症状,可能白带略有增多。

糜烂面占整个子宫口的之间,白带增多、颜色发黄、粘稠有异味。

糜烂面占整个宫颈面积的2/3以上,出现腰酸、下腹部重坠感,性生活出血。
宫颈糜烂4大常见病因
宫颈糜烂危害健康,要警惕!
引发深度病变
影响夫妻生活
影响女性受孕
增大癌变几率
据权威数据显示:已婚女性宫颈糜烂发病率高达80%-90%,已成为妇科第一高发病率疾病,对女性的危害甚大,需尽早到正规医院接受治疗。

宫颈糜烂检查确诊,要及时!
女性如有白带增多、腰酸腹痛、性交出血等症状,临床检查不可避免,临床检查对确诊疾病有重要作用,同时,根据检查结果医生也能制定诊疗方案。
碘试验和肉眼观察法

宫颈刮片细胞学检查

阴道镜检查

活体组织病理检查

紫荆专业治宫颈糜烂,更有效!
理由一:微创技术糜烂克星

作为一种非侵入性治疗方法,它通过电极尖端产生的高频电磁波在病灶产生强大能量...[详细]
理由二:专治妇科的医院更放心
襄阳紫荆妇产医院专业诊疗各类妇科疾病,能够有效开展宫颈糜烂手术,多年来,已经帮助无数女性还原光滑宫颈。详细了解医院>>

技术协作单位

健康工程单位

救助中心

医疗监管小组

标准手术室

安全保障体系
